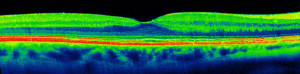
Dr-keane-hero

EU researchers discuss latest optometry research at City workshop

Workshop featured a variety of speakers and a Dean’s Lecture from Dr Pearse Keane on the Moorfields – DeepMind collaboration
https://www.city.ac.uk/news/2018/april/eu-researchers-discuss-latest-optometry-research-at-city-workshop
Artificial Intelligence in ophthalmology
Laura Edwards writes about the recent Dean’s Lecture by Dr Pearse Keane, a consultant ophthalmologist at Moorfields Eye Hospital
https://www.city.ac.uk/news/2018/april/artificial-intelligence-in-ophthalmology